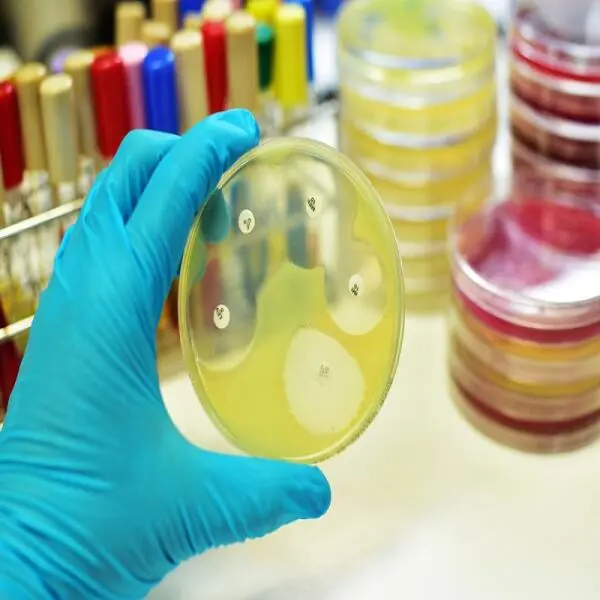
Kháng Sinh và Nuôi Tôm: Phân Tích Tác Động Kinh Tế và Môi Trường Khi Loại Bỏ

Đánh giá Khoáng CATO SAL – Giải pháp tối ưu cho việc nuôi tôm phát triển nhanh, khỏe mạnh và ngăn ngừa bệnh tật
Đánh giá Khoáng CATO SAL – Giải pháp tối ưu cho việc nuôi tôm phát triển nhanh, khỏe mạnh và ngăn ngừa bệnh tật
Nuôi tôm là một ngành nghề đòi hỏi người nuôi phải có kiến thức chuyên sâu và áp dụng đúng các biện pháp khoa học để tối ưu hóa sản lượng. Một trong những yếu tố quan trọng trong việc nuôi tôm là cung cấp đủ khoáng chất và amino acid thiết yếu. Sản phẩm Khoáng CATO SAL đang nổi bật trên thị trường nhờ vào công dụng vượt trội trong việc hỗ trợ tôm phát triển toàn diện. Bài review dưới đây sẽ phân tích chi tiết thành phần, hiệu quả thực tế và so sánh với các sản phẩm cùng loại để bạn có cái nhìn rõ ràng hơn về sản phẩm này.
Phân tích thành phần của Khoáng CATO SAL:
Khoáng CATO SAL được thiết kế với công thức tối ưu, chứa các thành phần chính giúp tôm hấp thu đầy đủ dưỡng chất để phát triển khỏe mạnh:
Magnesium (Mg): Magnesium đóng vai trò quan trọng trong việc duy trì hoạt động của cơ thể tôm. Magnesium giúp tôm duy trì sự cân bằng trong hệ thần kinh, giảm stress và hỗ trợ quá trình trao đổi chất. Đặc biệt, magnesium giúp tôm duy trì sức khỏe trong môi trường nuôi tôm thay đổi, hạn chế hiện tượng tôm bị ngừng ăn hoặc bị yếu cơ.
Potassium (K): Kali giúp tôm duy trì sự ổn định của hệ tim mạch và chức năng cơ bắp. Kali còn hỗ trợ quá trình trao đổi nước và muối trong cơ thể tôm, giúp tôm phát triển tốt trong các điều kiện môi trường thay đổi.
Glutamic acid: Là một loại amino acid thiết yếu, glutamic acid giúp tăng cường quá trình trao đổi chất, thúc đẩy sự tăng trưởng và phục hồi sức khỏe của tôm. Glutamic acid cũng hỗ trợ tôm tăng cường sức đề kháng đối với các bệnh nhiễm trùng do vi khuẩn và nấm.
Glycine: Glycine giúp cải thiện chức năng tiêu hóa của tôm và giúp tôm hấp thu thức ăn hiệu quả hơn. Điều này giúp tôm tăng trưởng nhanh và phát triển tốt ở tất cả các giai đoạn nuôi.
Arginine: Là một amino acid thiết yếu hỗ trợ quá trình tổng hợp protein và kích thích sự phát triển cơ bắp của tôm. Arginine cũng giúp tôm tăng cường khả năng lột xác đúng chu kỳ và đồng đều, giúp tôm có vỏ chắc khỏe hơn.
Các thành phần này kết hợp với nhau giúp tôm khỏe mạnh, tăng trưởng nhanh, và có khả năng chống lại các bệnh thường gặp trong môi trường nuôi.
Hiệu quả thực tế của Khoáng CATO SAL:
Sau khi sử dụng Khoáng CATO SAL trong thời gian dài, nhiều khách hàng đã quay lại mua với số lượng lớn và phản hồi tích cực về kết quả đạt được:
Tôm tăng trưởng nhanh và khỏe mạnh: Khoáng CATO SAL giúp tôm phát triển đồng đều ở tất cả các giai đoạn nuôi. Tôm ít mắc bệnh, ít bị ảnh hưởng bởi yếu tố môi trường, và có sức đề kháng cao hơn.
Lột xác đồng đều, đúng chu kỳ: Khoáng CATO SAL giúp tôm lột xác đúng chu kỳ, đồng đều, giảm thiểu tình trạng tôm bị lột xác không đều hoặc gặp phải các vấn đề về vỏ. Điều này rất quan trọng trong việc tăng tỷ lệ sống của tôm.
Ngăn ngừa bệnh tôm xanh, mềm vỏ, cong thân, đục cơ: Sản phẩm đã chứng minh được hiệu quả trong việc ngăn ngừa các bệnh tôm phổ biến, giúp tôm không bị mềm vỏ, cong thân hay đục cơ – những triệu chứng thường gặp khi tôm bị thiếu khoáng chất hoặc amino acid.
So sánh với các sản phẩm cùng loại:Trên thị trường hiện nay có nhiều sản phẩm khoáng và amino acid dành cho tôm, nhưng Khoáng CATO SAL nổi bật nhờ vào những điểm mạnh sau:
Thành phần cân đối: Nhiều sản phẩm khác chỉ chứa một vài loại khoáng chất hoặc amino acid, nhưng CATO SAL cung cấp một công thức hoàn chỉnh với đầy đủ các thành phần thiết yếu, giúp tôm phát triển toàn diện từ sức khỏe đến khả năng lột xác và chống bệnh.
Hiệu quả rõ rệt: Các sản phẩm khác có thể chỉ tác động vào một số vấn đề nhất định, như tăng cường sức đề kháng hoặc hỗ trợ lột xác, nhưng CATO SAL có thể giải quyết nhiều vấn đề cùng lúc, từ tăng trưởng đến ngăn ngừa bệnh tật.
Giá cả hợp lý: Với mức giá chỉ 119.000 đồng, CATO SAL mang lại hiệu quả vượt trội nhưng vẫn rất tiết kiệm, phù hợp cho các trại nuôi tôm quy mô lớn, giúp tiết kiệm chi phí mà vẫn đảm bảo hiệu quả cao.
sử dụng:
Liều lượng: Sử dụng Khoáng CATO SAL theo hướng dẫn trên bao bì, thường là hòa tan vào nước hoặc cho vào thức ăn tôm trong khoảng thời gian nhất định. Liều lượng nên được điều chỉnh tùy thuộc vào tình trạng sức khỏe và giai đoạn phát triển của tôm.
Kết hợp với các biện pháp chăm sóc khác:
Khoáng CATO SAL sẽ phát huy tối đa hiệu quả khi kết hợp với các biện pháp chăm sóc nuôi tôm như kiểm soát môi trường nước, cung cấp thức ăn chất lượng và theo dõi sức khỏe tôm định kỳ.
Theo dõi kết quả: Sau một vài tuần sử dụng, bạn nên theo dõi sự thay đổi trong việc phát triển và sức khỏe của tôm để điều chỉnh kịp thời.
Kết luận:
Khoáng CATO SAL là một sản phẩm vô cùng hiệu quả cho việc nuôi tôm, giúp tôm phát triển mạnh mẽ, khỏe mạnh và giảm thiểu bệnh tật. Với công thức chứa đầy đủ các khoáng chất và amino acid thiết yếu, sản phẩm này không chỉ giúp tôm tăng trưởng nhanh mà còn giúp bảo vệ sức khỏe của tôm trong suốt quá trình nuôi. So với các sản phẩm cùng loại, CATO SAL mang lại hiệu quả vượt trội với mức giá hợp lý, là một lựa chọn lý tưởng cho các trại nuôi tôm.